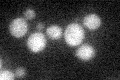
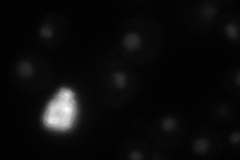
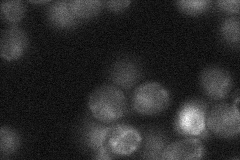
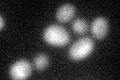
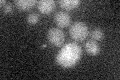

View description
Transcription factor of the Zn[II]2Cys6 family involved in sterol uptake; involved in induction of hypoxic gene expression
Localization:
Intensity:
Fold change:
Significance:
-
C’ GFP library in SD
cytosol18.6 -
N' NOP1pr-GFP in SD
nucleolus24.1685 -
N' TEF2pr-mCherry in SD

cell periphery,vacuole0 -
N' NATIVEpr-GFP in SD
nucleus22.7152 -
N' TEF2pr-VC and Cyto-VN in SD

#N/A0 -
C’ GFP library in SD+DTT
cytosol18.170.97No -
C’ GFP library in SD+H2O2

cytosol14.270.76No -
C’ GFP library in Starvation Media
cytosol14.80.79No -
C’ GFP library on the background of Pup2-DaMP

cytosol -
C’ GFP library on the background of CCT mutant

cytosol17.68740.950771No
